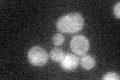
YOL081W
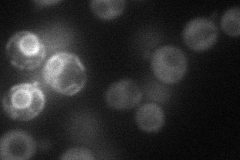
YOL081W
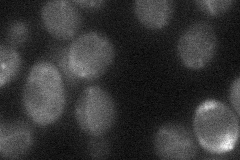
YOL081W
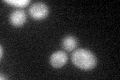
YOL081W
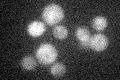
YOL081W

View description
GTPase-activating protein that negatively regulates RAS by converting it from the GTP- to the GDP-bound inactive form, required for reducing cAMP levels under nutrient limiting conditions, has similarity to Ira1p and human neurofibromin
Localization:
Intensity:
Fold change:
Significance:
-
C’ GFP library in SD
cytosol25.37 -
N' NOP1pr-GFP in SD
cytosol42.9582 -
N' TEF2pr-mCherry in SD

cytosol,punctate18.2783 -
N' NATIVEpr-GFP in SD

below threshold21.836 -
N' TEF2pr-VC and Cyto-VN in SD
below threshold26.7489 -
C’ GFP library in SD+DTT
cytosol26.191.03No -
C’ GFP library in SD+H2O2

cytosol23.540.92No -
C’ GFP library in Starvation Media
cytosol28.381.11No -
C’ GFP library on the background of Pup2-DaMP

cytosol -
C’ GFP library on the background of CCT mutant

cytosol19.23250.75774No
